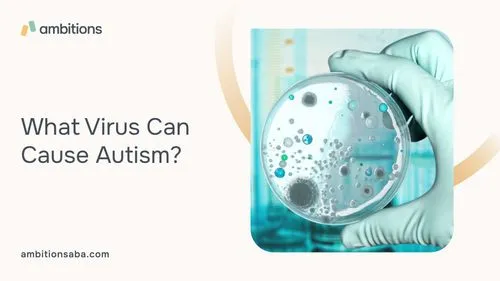

The Connection Between Viruses and Autism
The idea that viruses could cause autism has been circulating for many years, but it remains a highly debated topic among scientists. While some studies have suggested a possible link between certain viruses and autism development, the evidence is inconclusive and further research is necessary to establish a causal relationship.
One theory is that viruses may alter the brain's development or immune system, leading to the development of autism. However, this theory has not been fully proven and many researchers are still skeptical. Despite this, the possibility of a link between viruses and autism continues to be explored.
The cause of autism is still largely unknown, and while research has shed some light on possible contributing factors, there is still much to learn.
As we continue to study and understand autism, it's crucial that we remain open-minded and continue to explore all possible avenues for a better understanding of this complex condition.
The Most Researched Viruses
Rubella Virus
The rubella virus is one of the most studied viruses in relation to autism. Rubella is a contagious viral infection that can cause a mild fever and rash. If a woman contracts rubella during pregnancy, it can lead to serious birth defects, including autism.
Although rubella has been virtually eliminated in developed countries thanks to vaccination programs, it's still prevalent in some parts of the world.
Cytomegalovirus
Cytomegalovirus (CMV) is a common virus that usually doesn't cause symptoms in healthy people. However, it can be dangerous for people with weakened immune systems and pregnant women.
Some studies have suggested that CMV infection during pregnancy may increase the risk of autism. However, the evidence is still limited, and more research is needed to establish a causal link.
Herpes Simplex Virus
Herpes simplex virus (HSV) is a common virus that causes cold sores, genital herpes, and other infections. Some studies have suggested that HSV infection during pregnancy may increase the risk of autism in the offspring. However, the evidence is still unclear, and more research is needed to confirm this link.
Influenza Virus
Influenza, or the flu, is a contagious respiratory illness caused by the influenza virus. Some studies have suggested that maternal infection with the influenza virus during pregnancy may increase the risk of autism in the offspring. However, the evidence is still limited, and more research is needed to establish a causal relationship.

The Role of Other Viruses in Autism Development
While rubella, cytomegalovirus, herpes simplex virus, and influenza virus have been the most researched viruses in relation to autism, other viruses may also play a role in autism development.
For example, some studies have suggested a link between maternal infection with enteroviruses during pregnancy and an increased risk of autism in the offspring. Enteroviruses are a group of viruses that can cause various illnesses, including hand-foot-and-mouth disease and meningitis.
In addition to enteroviruses, other viruses such as human herpesvirus 6 (HHV-6) and parvovirus B19 have also been studied in relation to autism. HHV-6 is a common virus that causes roseola, a mild childhood illness characterized by a high fever and rash.
Some studies have suggested that maternal infection with HHV-6 during pregnancy may increase the risk of autism in the offspring. Parvovirus B19 is another common virus that can cause fifth disease, a mild childhood illness characterized by a rash on the face and body.
While some studies have suggested a possible link between parvovirus B19 infection during pregnancy and an increased risk of autism, the evidence is still limited.
Overall, while much research has focused on rubella, cytomegalovirus, herpes simplex virus, and influenza virus as potential contributors to autism development, it's important to consider the role of other viruses as well.
Further research is needed to fully understand how different viruses may interact with genetic and environmental factors to contribute to the development of this complex condition.
How CMV Infection Affects the Developing Brain?
Cytomegalovirus (CMV) infection during pregnancy has been associated with several neurological complications, including hearing loss, microcephaly, and intellectual disability. Studies have shown that CMV can directly affect the developing brain by infecting neural stem cells and disrupting their normal development.
The virus can also cause inflammation in the fetal brain, which can lead to damage to neurons and other brain cells. This damage can result in long-term cognitive and behavioral deficits, including an increased risk of autism.
Although not all children born to mothers with CMV infection during pregnancy will develop neurological complications or autism, it's important to be aware of the potential risks associated with this virus.
Pregnant women should take precautions to avoid exposure to CMV, such as washing their hands frequently and avoiding close contact with young children who may be carrying the virus.
Further research is needed to fully understand how CMV infection affects the developing brain and its potential role in autism development. However, it's clear that preventing maternal CMV infection during pregnancy is crucial for ensuring optimal neurodevelopmental outcomes for children.
The Latest Research on the Link Between Rubella and Autism
While rubella has been virtually eliminated in developed countries thanks to vaccination programs, it still remains a concern in developing regions. Recent research has shed some light on the possible link between rubella and autism.
A study published in the Journal of Autism and Developmental Disorders found that children with autism were more likely to have been exposed to rubella during their mother's pregnancy compared to children without autism.
The study analyzed blood samples from mothers of children with and without autism and found that mothers of children with autism had higher levels of rubella antibodies.
Another study published in the journal Frontiers in Psychiatry found that maternal infection with rubella during pregnancy was associated with an increased risk of autism spectrum disorder (ASD) in offspring.
The study analyzed data from over 1 million Swedish children born between 1984 and 2007, and found that maternal infection with rubella during the first trimester of pregnancy was associated with a 25% increased risk of ASD.
These studies suggest that rubella may play a role in the development of autism, but more research is needed to establish a causal relationship. It's important for pregnant women to get vaccinated against rubella if they haven't already, as this can help prevent complications associated with this virus.

Possible Mechanisms Through Which Viruses Could Cause Autism
Researchers have been exploring various mechanisms through which viruses could potentially cause autism. One theory is that viral infections during pregnancy may lead to inflammation in the fetal brain, which can disrupt normal brain development and contribute to the development of autism.
Another possible mechanism is that viruses may directly infect neural stem cells, which are responsible for producing new neurons in the developing brain. This can lead to abnormalities in brain structure and function, contributing to the development of autism.
It's also possible that viral infections during pregnancy may affect the immune system, leading to an increased risk of autoimmune disorders that have been linked to autism.
For example, some studies have suggested a link between maternal infection with the flu virus during pregnancy and an increased risk of autoimmune disorders such as type 1 diabetes in offspring.
Finally, some researchers have proposed a "two-hit" model for autism development, where genetic susceptibility and environmental factors such as viral infections interact to increase the risk of developing autism. In this model, viral infections may act as a second hit that triggers or exacerbates underlying genetic vulnerabilities.
While these mechanisms are still being explored and researched, they provide insight into how viruses could potentially contribute to the development of autism. As we continue to study and understand this complex condition, it's crucial that we consider all possible avenues for prevention and treatment.
Other Factors That May Contribute to Autism Development
While viruses have been one area of research in the study of autism development, there are other factors that may play a role as well. One potential contributing factor is exposure to environmental toxins during pregnancy.
Studies have shown that exposure to certain chemicals, such as pesticides, lead, and mercury, may increase the risk of autism. These toxins can cross the placenta and affect fetal brain development, leading to long-term cognitive and behavioral deficits.
In addition to environmental toxins, stress during pregnancy may also contribute to autism development. Research has suggested that maternal stress during pregnancy may increase the risk of autism in offspring. Stress can affect fetal brain development by altering gene expression and disrupting normal cellular processes.
It's important for pregnant women to take steps to minimize their exposure to environmental toxins and manage stress levels during pregnancy. This can include eating a healthy diet, avoiding smoking and alcohol consumption, getting regular exercise, and practicing relaxation techniques such as yoga or meditation.
Further research is needed to fully understand how environmental toxins and stress may contribute to autism development. However, it's clear that taking steps to promote a healthy pregnancy can help ensure optimal neurodevelopmental outcomes for children.
The Importance of Early Intervention for Children with Autism Spectrum Disorder
Early intervention is crucial for children with autism spectrum disorder (ASD) to achieve their full potential. Research has shown that early diagnosis and treatment can greatly improve outcomes for children with ASD.
One of the main goals of early intervention is to help children with ASD develop communication and social skills. This can include speech therapy, occupational therapy, and behavioral therapy. These therapies can help children learn how to communicate effectively, interact with others, and manage challenging behaviors.
Another important aspect of early intervention is providing support to families. Raising a child with ASD can be challenging, and parents may feel overwhelmed or unsure about how to best support their child. Early intervention services can provide guidance and resources to help families navigate the challenges of raising a child with ASD.
It's important for parents to seek out early intervention services as soon as they suspect their child may have ASD. The earlier a child receives treatment, the better the outcomes are likely to be. Delaying treatment can lead to missed opportunities for learning and development.
In addition to improving outcomes for individual children, early intervention also has broader societal benefits. By helping children with ASD develop communication and social skills at an early age, we can increase their chances of success in school and later in life.
This can lead to improved quality of life for individuals with ASD and reduced costs associated with supporting them throughout their lifetime.
Overall, early intervention is a critical component of supporting children with ASD and promoting positive outcomes. It's important for parents and caregivers to seek out early intervention services as soon as possible if they suspect their child may have ASD.
With appropriate support, children with ASD can achieve their full potential and thrive in all aspects of life.
FAQs
Can any virus cause autism?
While some studies have suggested a link between certain viruses and an increased risk of autism, not all children who are exposed to these viruses will develop autism.
Autism is a complex condition that likely involves a combination of genetic and environmental factors. Further research is needed to fully understand the role of viruses in autism development.
Is there a cure for autism?
Currently, there is no known cure for autism. However, early intervention and treatment can greatly improve outcomes for individuals with autism.
Treatment may include therapies such as speech therapy, occupational therapy, and behavioral therapy. Medications may also be used to treat specific symptoms associated with autism, such as anxiety or hyperactivity.
Are vaccines responsible for causing autism?
No. Numerous studies have shown that vaccines do not cause autism. The original study that suggested a link between vaccines and autism has been thoroughly discredited and retracted by the journal in which it was published.
Vaccines are safe and effective at preventing serious illnesses, including those caused by viruses that have been studied in relation to autism.
Can I prevent my child from developing autism?
While there is no guaranteed way to prevent autism, there are steps you can take to promote healthy neurodevelopment during pregnancy and early childhood.
This includes getting regular prenatal care, avoiding exposure to environmental toxins such as lead or pesticides, managing stress levels during pregnancy, and seeking out early intervention services if you suspect your child may have developmental delays.
What should I do if I suspect my child may have autism?
If you suspect your child may have developmental delays or signs of ASD, it's important to seek out medical evaluation as soon as possible. Your pediatrician can refer you to specialists who can conduct diagnostic testing and provide recommendations for treatment and support services.
Early intervention is crucial for improving outcomes for children with ASD, so it's important to seek out evaluation and treatment as soon as possible.
Conclusion
While there is some evidence linking viruses to autism, the subject is still a matter of debate. The most researched viruses in this context are rubella, cytomegalovirus, herpes simplex virus, and influenza virus.
More research is needed to establish a causal relationship between these viruses and autism. It's important to remember that autism is a complex disorder that can have various causes and that vaccines do not cause autism.



